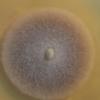

Phaeosphaeriopsis glaucopunctata
Angel Pintos
, 26-02-2017 10:59
| Genre | Phaeosphaeriopsis |
|---|---|
| Espèce | glaucopunctata |
| Autorités | (Grev.) M.P.S. Câmara, M.E. Palm & A.W. Ramaley |
| Classe | Dothideomycetes |
| Sous-Classe | |
| Ordre | Pleosporales |
| Famille | Phaeosphaeriaceae |
| Substrat | Ruscus aculeatus |
| Herbier | AP22117A |
| Localité | Esporlas (Mallorca) |
| Pays | Espagne |
| Leg. | Angel Pintos |
| Det. | Angel Pintos |
| Date de récolte | 22-01-2017 |
| Remarque |